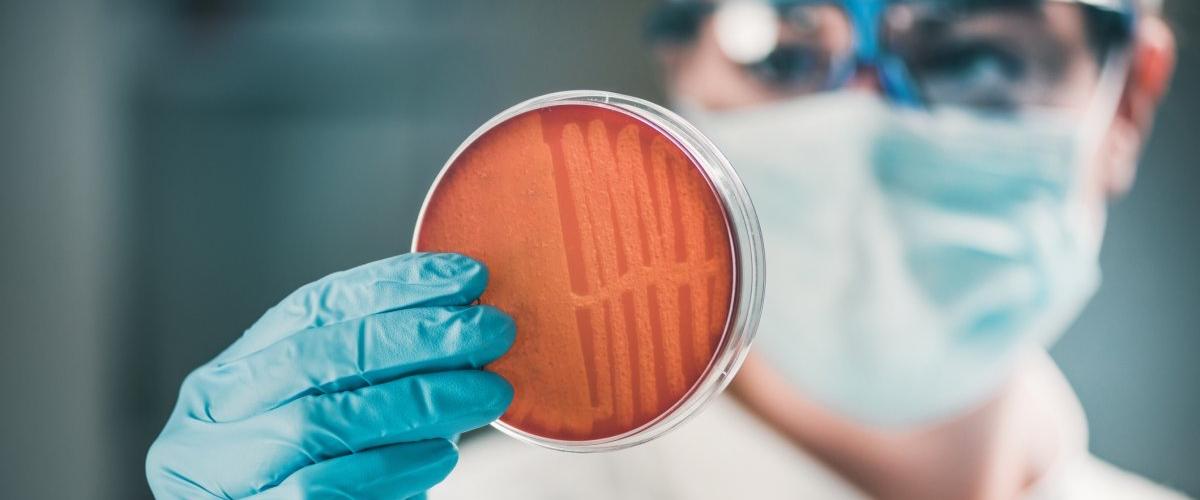
TODO:

Исследователи проанализировали данные о смертности и медицинские карты из 204 стран в период с 1990 по 2021 год. Команда сосредоточилась на 22 патогенах, 84 комбинациях бактерий и лекарств, к которым они устойчивы, и 11 заболеваниях, включая инфекции крови и менингит.
Результаты исследования показывают, что число детей в возрасте до пяти лет, умирающих от инфекций, устойчивых к лекарственным препаратам, за последние 30 лет сократилось более чем на 50%. Однако показатели смертности среди людей старше 70 лет выросли на 80%. Самый большой рост, на 90,29%, наблюдался среди смертей от инфекций, вызванных золотистым стафилококком, который поражает кожу, кровь и внутренние органы.
Многие из самых смертоносных инфекций между 1990 и 2021 годами были вызваны группой бактерий с особенно сильной лекарственной устойчивостью — грамотрицательными бактериями. Эта категория включает Escherichia coli и Acinetobacter baumannii — патогены, связанные с внутрибольничными инфекциями.
Граммотрицательные бактерии устойчивы к карбапенемам — классу антибиотиков, используемых для лечения тяжелых инфекций. Они могут обмениваться генами устойчивости к антибиотикам с различными видами, а также передавать их потомству. Смерти, связанные с устойчивыми к карбапенемам грамотрицательными бактериями, увеличились на 149,51% с 50 900 случаев в 1990 году до 127 000 случаев в 2021 году.
Согласно отчету, к 2050 году устойчивость к антимикробным препаратам может ежегодно вызывать 1,91 млн смертей, а еще 8,22 млн человек умрут от заболеваний, связанных с устойчивостью. Более 65% смертей, связанных с резистентностью к антимикробным препаратам в 2050 году, произойдут среди людей старше 70 лет.
Регионы с самыми высокими прогнозируемыми показателями смертности включают Южную Азию, Латинскую Америку и страны Карибского бассейна. Ученые подчеркивают, что любые стратегии по борьбе с лекарственной устойчивостью должны быть ориентированы в первую очередь на страны с низким и средним уровнем дохода.
Исследователи призывают политиков обратить внимание на проблему чрезмерного использования антибиотиков в сельском хозяйстве, поскольку это ускоряет развитие устойчивости бактерий. Также они предлагают увеличить финансирование исследований для разработки новых антибиотиков. Авторы надеются, что их отчет станет руководством для разработки новых лекарственных препаратов.